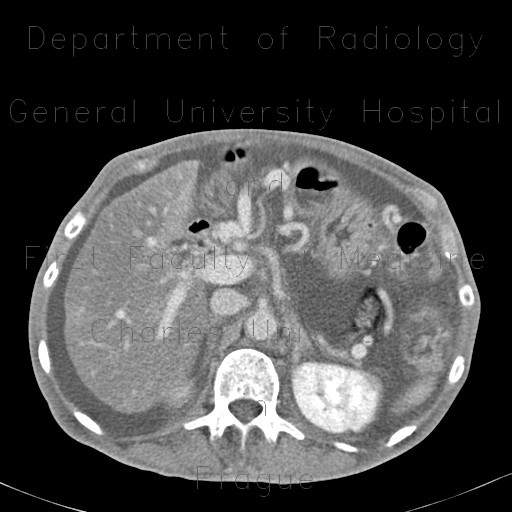
Venous congestion, thrombosis of superior mesenteric vein, ascites, steatosis of liver

ATLAS OF RADIOLOGICAL IMAGES v.1
General University Hospital and 1st Faculty of Medicine of Charles University in Prague
Venous congestion, thrombosis of superior mesenteric vein, ascites, steatosis of liver
CASE
CT shows marked enhancement of the inner layer of colonic wall, edema of bowel wall - both small and large bowel, massive dilatation and tortuosity of mesenteric veins with shunting due to occlusion of superior mesenteric vein. Note also the presence of ascites and decreased density of liver parenchyma due to steatosis.